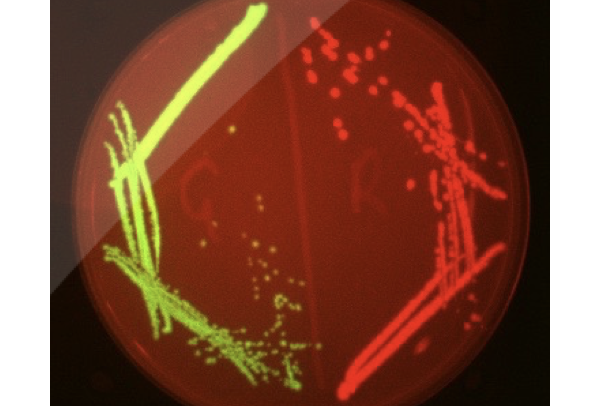
collage image title

-

5700100292_2077828fcf_o
-

5287697877_76c5812207_o
-

11092983355_d7d2beee34_b
-

5250048656_1675a2e2a2_o
-

10791787445_c149342e84_o
-

5299665267_a5e4c5b407_o
-

5413474678_9d384a36da_o
-

5445544545_0a086f5888_o
-

5746117695_628c446de9_o
-

5782441273_e3439a325f_o
-

5785736047_94900bcf09_o
-

5937639152_86026d468f_o
-

5937640654_7af6f69ff1_o
-

5986868137_e265914be4_o
-

6086539442_9ce75b7f2c_o
-

6021978067_ce9ab10865_o
-

6029148511_c1de523954_o
-

6150777807_7d65f1b81f_o
-

6150806731_3bb8c4f68b_o
-

6151356008_d1bdc31eb0_o
-

6156600148_63778f5c35_o
-

6193341910_9ebb5c23c5_o
-

6331834138_4e44ea1b32_o
-

8376844541_179c64f006_o
-

8941539494_3d113a4c28_o
-

8948334490_86e7c5c903_o
-

9681290697_f522a4b9db_o
-

Bsub_sfGFP_280212_Image001-OrthoSlice.0000
-

Bsub_sfGFP_280212_Image003-OrthoSlice.0000
-

Bsub_sfGFP_280212_Image005-OrthoSlice.0000
-

Bsub_sfGFP_280212_Image007-OrthoSlice.0000
-

Bsub_sfGFP_280212_Image009-OrthoSlice.0000
-
GFP+RFPplate
-

IMG_4116
-

PlantSyntheticBiology2012_Lect4.004